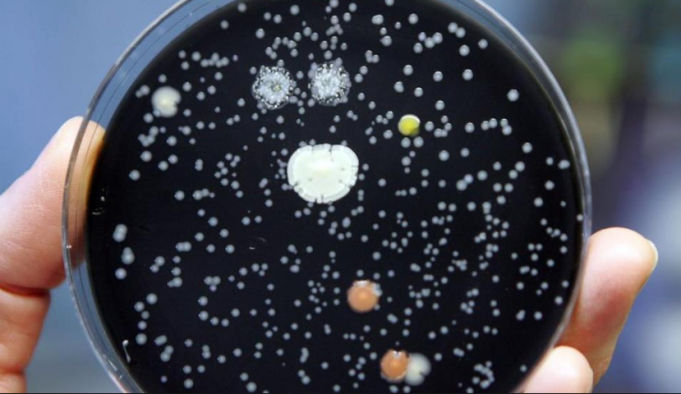

Una commercialista cagliaritana di 62 anni, Simona Caddeo, è morta dopo il ricovero all’ospedale Brotzu di Cagliari per complicanze di una polmonite causata da un’infezione batterica di legionellosi. A riportare la notizia è un noto quotidiano locale.
La donna, appena rientrata da un viaggio a Varese dove aveva alloggiato in un albergo, aveva accusato quasi subito febbre e debolezza.
Tre giorni fa è andata per una visita al pronto soccorso: gli è stata diagnosticata l’infezione ed è stata ricoverata nel reparto di Medicina dove è stata avviata la terapia. Le sue condizioni, però, sono peggiorate ed è stata trasferita in Rianimazione, ma la 62enne è morta.
Ora potrebbero scattare i controlli sanitari negli ambienti frequentati dalla donna negli ultimi giorni a Cagliari e del centro lombardo.